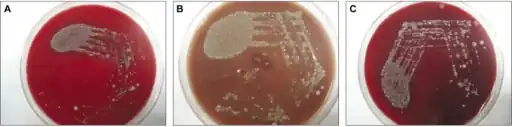
Comparison a)Blood agar b) chocolate agar  c)   MacConkey agar

Chocolate agar

Known as overgrowth, the nonselective chocolate agar medium on the left, due to its composition, allowed for the growth of organismal colonies other than those of N. gonorrhoeae, while the selective Thayer–Martin medium on the right, containing antimicrobials that inhibit the growth of organisms other than N. gonorrhoeae, shows no overgrowth, but is positive for N. gonorrhoeae bacteria. (Enlarge image to see N. gonorrhoeae colonies)
Chocolate agar (CHOC) or chocolate blood agar (CBA), is a nonselective, enriched growth medium used for isolation of pathogenic bacteria.[1][2][3] It is a variant of the blood agar plate, containing red blood cells that have been lysed by slowly heating to 80°C. Chocolate agar is used for growing fastidious respiratory bacteria, such as Haemophilus influenzae and Neisseria meningitidis.[4] In addition, some of these bacteria, most notably H. influenzae, need growth factors such as nicotinamide adenine dinucleotide (factor V or NAD) and hemin (factor X), which are inside red blood cells; thus, a prerequisite to growth for these bacteria is the presence of red blood cell lysates. The heat also inactivates enzymes which could otherwise degrade NAD. The agar is named for its color and contains no chocolate products.
Variants
Chocolate agar with the addition of bacitracin becomes selective for the genus Haemophilus. Another variant of chocolate agar called Thayer–Martin agar contains an assortment of antibiotics which select for Neisseria species.
Composition of Chocolate Agar Medium
The composition of chocolate agar includes the following components: [5]
| Ingredient | Quantity (Grams per liter) | Purpose |
|---|---|---|
| Casein/Animal Tissue Digest | 15.0 Grams | Source of amino acids and peptides for bacterial growth. |
| Cornstarch | 1.0 Grams | Provides carbohydrates as an energy source for bacteria. |
| Sodium Chloride | 5.0 Grams | Maintains osmotic balance in the medium. |
| Dipotassium Phosphate | 4.0 Grams | Acts as a pH buffer to maintain the desired pH for bacterial growth. |
| Monopotassium Phosphate | 1.0 Grams | Acts as a pH buffer to maintain the desired pH for bacterial growth. |
| Hemoglobin Solution 2% | 500 ml | Provides iron and other nutrients necessary for bacterial growth. |
| Coenzyme Enrichment | 10 ml | Contains coenzymes needed for specific metabolic pathways of bacteria. |
| Agar | 10 Grams | Solidifying agent that allows the medium to form a solid surface for bacterial growth. |
The exact concentrations of these ingredients may vary slightly depending on the specific formulation used in different laboratories or by different manufacturers.
Comparison a)Blood agar b) chocolate agar c) MacConkey agar
Comparison a)Blood agar b) chocolate agar c) MacConkey agar Chocolate agar showing Francisella tularensis colonies
Chocolate agar showing Francisella tularensis colonies
References
- ↑ Segen. "Chocolate agar: Definition". The Free Dictionary. Archived from the original on 15 November 2014. Retrieved 28 September 2012.
- ↑ "Chocolate Agar (CHOC)". Anaerobe free systems. Archived from the original on 5 October 2012. Retrieved 28 September 2012.
- ↑ Anderson, Cindy (2013). Great Adventures in the Microbiology Laboratory (7th ed.). Pearson. p. 175. ISBN 978-1-269-39068-2.
- ↑ Gunn, B.A (1984). "Chocolate agar: A differential medium for gram positive cocci". Journal of Clinical Microbiology. 20 (4): 822–823. doi:10.1128/jcm.20.4.822-823.1984. PMC 271442. PMID 6490866.
- ↑ "Chocolate Agar media - Preparation and Uses - Laboratoryinfo.com". laboratoryinfo.com. 13 January 2021. Archived from the original on 3 June 2023. Retrieved 28 September 2023.